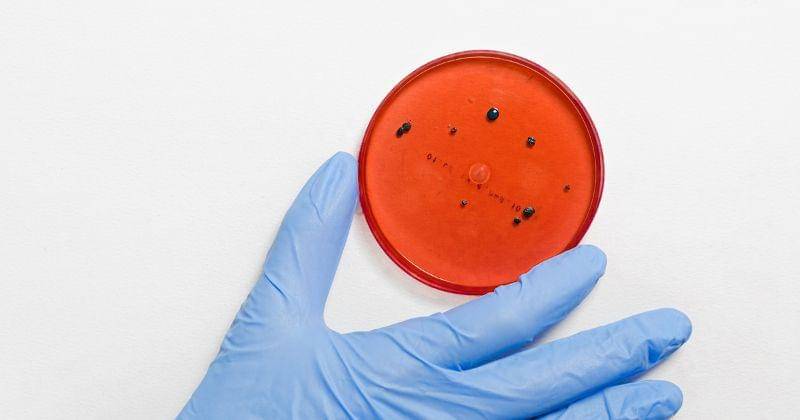
Pexels/Anna Shvets

Kemenkes Temukan 6 Varian Covid-19 Kraken, Dua Pasien PPLN

Kementerian Kesehatan (Kemenkes) RI telah mengumumkan penemuan enam kasus Covid-19 varian Kraken di Indonesia. Diketahui dari keenam pasien tersebut, dua di antaranya merupakan Pelaku Perjalanan Luar Negeri (PPLN) dari Polandia dan umrah.
Terdapat satu pasien perempuan berusia 46 tahun yang sudah melakukan vaksinasi booster. Dirinya tidak bisa ditindaklanjut dalam penyelidikan epodemiologi karena tidak tinggal di alamat yang diberikan.
Hal ini disampaikan langsung oleh Juru Bicara Kemenkes, Mohammad Syahril, dalam siaran tertulis pada Selasa (21/2/2023).
"Terkait hal itu, sudah dikomunikasikan ke pengurus desa setempat, dan pasien saat ini sudah dinyatakan sembuh," ujar Mohammad Syahril.
Informasi Covid-19 yang cukup penting nih, Ma. Mari kita simak penjelasan selengkapnya yang telah Popmama.com rangkum mengenai Kemenkes temukan enam varian Covid-19 Kraken secara lebih detail.
1. Pasien kedua sudah melakukan vaksinasi booster

Tidak hanya pasien berusia 46 tahun saja yang sudah mendapatkan vaksinasi booster sebelum terkena Covid-19 Kraken. Seorang perempuan berusia 22 tahun juga diketahui status vaksinasinya sudah booster lebih dari enam bulan.
"Gejalanya ringan tanpa komorbid, saat ini sudah selesai melaksanakan isolasi mandiri dan dinyatakan sembuh," ungkap Mohammad Syahril.
2. Total terdapat enam pasien varian Kraken

Pasien ketiga merupakan laki-laki berusia 47 tahun, dan pasien keempat yaitu perempuan berusia 37 tahun. Saat ini, keduanya tengah diproses dalam penyelidikan epidemiologi.
"Sejak Desember 2022 kita ada satu pasien, Januari tambah 5 pasien jati total saat ini ada 6 pasien. Gejala pada pasien ini 4 di antaranya tidak bergejala dan dua pasian dengan gejala ringan," kata Mohammad Syahril.
3. Varian virus Kraken penularannya lebih cepat
Juru Bicara Kemenkes mengungkapkan bahwa varian virus Kraken memiliki karakter penularan yang lebih cepat, apabila dibandingkan dengan sub varian sebelumnya.
Selain itu juga masih belum ada bukti yang cukup untuk menunjukkan tingkat kesakitan, dan kematian akibat orthrus lebih para dari sub varian sebelumnya.
"Walaupun kasus Covid-19 varian Kraken terlaporkan di Indonesia, sampai saat ini perkembangan Covid-19 di Indonesia masih terkendali," ujarnya.
Nah Ma, itulah informasi mengenai Kemenkes temukan enam varian Covid-19 Kraken. Tetap terus berwaspada dan selalu jaga kesehatan keluargamu ya, Ma.



















